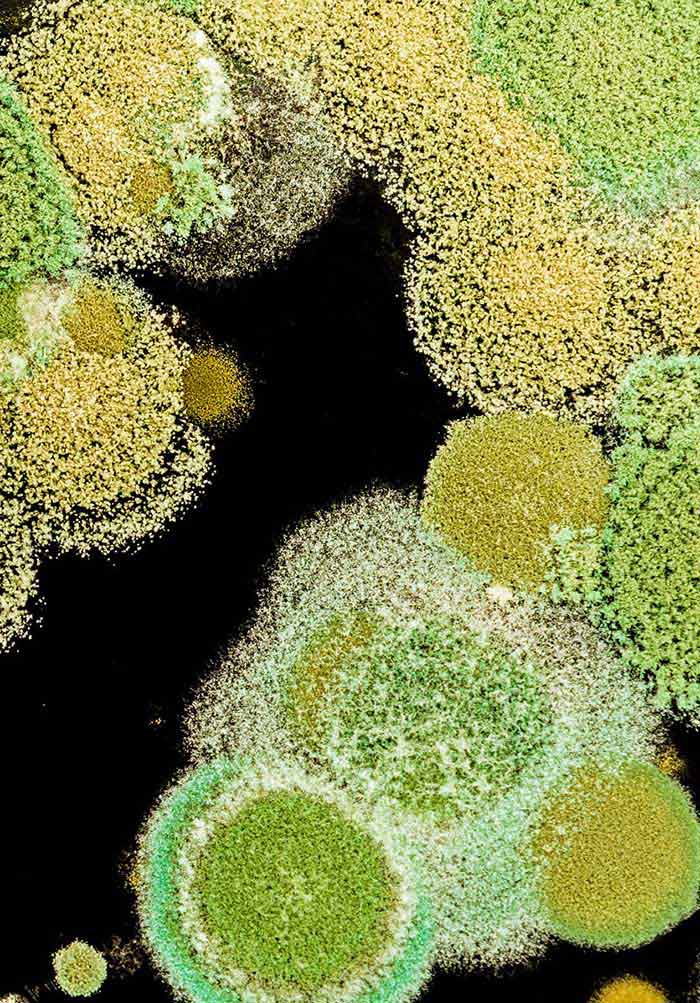

ট্রাইকোডার্মা হচ্ছে মাটিতে মুক্তভাবে বসবাসকারি উপকারি ছত্রাক- যা উদ্ভিদের শিকড়স্থ মাটি, পঁচা আবর্জনা ও কম্পোস্ট ইত্যাদিতে অধিক পরিমাণে পাওয়া যায়।
এটি মাটিতে বসবাসকারি উদ্ভিদের ক্ষতিকর জীবাণু যেমন- ছত্রাক, ব্যাকটেরিয়া ও নেমাটোডকে মেরে ফেলে। ট্রাইকোডার্মা প্রকৃতি থেকে আহরিত এমনই একটি অণুজীব যা জৈবিক পদ্ধতিতে উদ্ভিদের রোগ দমনে ব্যবহার করা হচ্ছে।
ট্রাইকোডার্মা বায়োপেস্টিসাইডটি প্রথম আবিষ্কার করেন বাংলাদেশ কৃষি বিশ্ববিদ্যালয়ের উদ্ভিদ রোগতত্ত্ব বিভাগের অধ্যাপক ড.মো.বাহাদুর মিয়া যা ২০১৩ সালের জুন মাসে বগুড়া আরডিএ ল্যাবরেটরীতে গবেষণার মাধ্যমে কৃষকদের ব্যবহার উপযোগী করে তোলা হয়।
ট্রাইকোডার্মার ব্যবহার ও উপকারিতা: এটি ট্রাইকো-সাসপেনশন, পাউডার এবং পেস্ট আকারে উৎপাদন সম্ভব। নিয়মানুযায়ী স্প্রে করলেই এর কার্যকারিতা পাওয়া যায়। পঁচা আবর্জনায় ‘ট্রাইকো-সাসপেনশন’- এর জলীয় দ্রবণ মিশিয়ে দ্রুত সময়ে ট্রাইকো-কম্পোস্ট উৎপাদন করা সম্ভব। এটি সহজলভ্য হওয়ায় রাসায়নিক সার ও কীটনাশক ব্যবহারের প্রয়োজন হবে না। এর ব্যবহারে বিষমুক্ত ফসল উৎপাদন সম্ভব।
বীজশোধনে ও মাটিবাহিত উদ্ভিদের রোগ দমনে কার্যকর ভূমিকা রাখে। এছাড়াও উদ্ভিদের বৃদ্ধি ও ফসল উৎপাদনে সহায়তা করে ট্রাইকোডার্মা। এর ব্যবহারে কৃষিতে উৎপাদন ব্যয় সাশ্রয় হয়। জমিতে কোন ক্ষতিকর প্রভাব পড়ে না। মাটির উর্বরা শক্তি বাড়ায়। রাসায়নিক সারের ব্যবহার কমায় ৪০%-৬০%।
ট্রাইকো কম্পোস্ট তৈরির পদ্ধতিঃ ভার্মি ও ট্রাইকো কম্পোস্ট তৈরির প্রক্রিয়া প্রায় একই। তবে ভার্মি কম্পোস্ট থেকে শুধু জৈব সার পাওয়া যায়, অন্যদিকে ট্রাইকো কম্পোস্ট থেকে সার ও বালাইনাশক দুটোই মিলছে। যে কারণে এ সারের জনপ্রিয়তা দিন দিন বাড়ছে।
এই সার বসতবাড়িতেই তৈরি করা যায়। তেমন কোনো খরচও নেই। সার তৈরির জন্য প্রয়োজন তিন ফুট ব্যাসের তিনটি ইট-সিমেন্টের রিং, যেগুলো পলিথিনের ওপর পরপর সাজিয়ে হাউজ তৈরি করতে হয়। এরপর পরিমাণমতো গোবর, কাঠের গুঁড়া, মুরগির বিষ্ঠা, কচুরিপানা, ছাই, নিমপাতা, ট্রাইকোডার্মা পাউডার, চিটাগুড়, ভুট্টা ভাঙা দিয়ে ভালোভাবে মেশাতে হয়। পরে মিশ্রণটি হাউজে দিয়ে পরিমাণমতো পানি দিতে হবে। এরপর হাউজটি একটি টিনের চালা দিয়ে ঢেকে দিতে হয়। মিশ্রণটি চার-পাঁচদিন পরপর ভালোভাবে নেড়ে দিতে হবে। তা না হলে গ্যাসের চাপে রিং ফেটে যেতে পারে। ৪০-৪৫ দিনের মধ্যেই সার তৈরি হয়ে ব্যবহারের উপযোগী হয়।
এ পদ্ধতিতে রিং দিয়ে তৈরি হাউজের পাশে একটি ছোট গর্ত করে রাখতে হবে, যাতে হাউজ থেকে বের হওয়া লিসেট (তরল পদার্থ) সেখানে জমা হতে পারে। এ তরলই বালাইনাশক হিসেবে ব্যবহার করা হয়।
ট্রাইকোডার্মা জৈব সারের উপকারিতা: ট্রা্ইকো-জৈব সার মাটিতে বসবাসকারী ট্রাইকোডার্মা ও অন্যান্য উপকারী অনুজীবের সংখ্যা বাড়িয়ে অনুর্বর মাটিকে দ্রুত উর্বরতা দান করে এবং ক্ষতিকর ছত্রাককে ধংস করে।
মাটির গঠন ও বুনট উন্নত করে পানি ধারণ ক্ষমতা বাড়ায়। পানির অপচয় রোধ ও সেচ খরচ কম হওয়ার ফলে কৃষকের আর্থিক সাশ্রয় হয়।
মাটির অম্লতা, লবনাক্ততা, বিষক্রিয়া প্রভৃতি রাসায়নিক বিক্রিয়াকে নিয়ন্ত্রণ করতে সক্ষম।
মাটি ও ফসলের রোগবালা্ই নিয়ন্ত্রণের মাধ্যমে রাসায়নিক বালাইনাশক ব্যবহারকে নিরুৎসাহিত করার ফলে পরিবেশের উন্নতি ঘটে এবং বিষমুক্ত খাদ্য-শস্য উৎপাদনের সম্ভাবনাকে বহুগুনে বাড়িয়ে দেয়।
গাছের প্রয়োজনীয় খাদ্য উপাদানের বেশির ভাগের উপস্থিতির কারনে কমপক্ষে৩০% রাসায়নিক সার সাশ্রয় হয় বলে কৃষকের উৎপাদন খরচ কমে আসে।
ফসলের উৎপাদন ও গুণগতমান বাড়িয়ে কৃষকের আয় বৃদ্ধিতে সহায়তা করে।
bdview24.com — বিডিভিউ২৪.কম Bangla News from Bangladesh regarding politics, business, lifestyle, culture, sports, crime. bdview24 send you all Bangla News through the day.